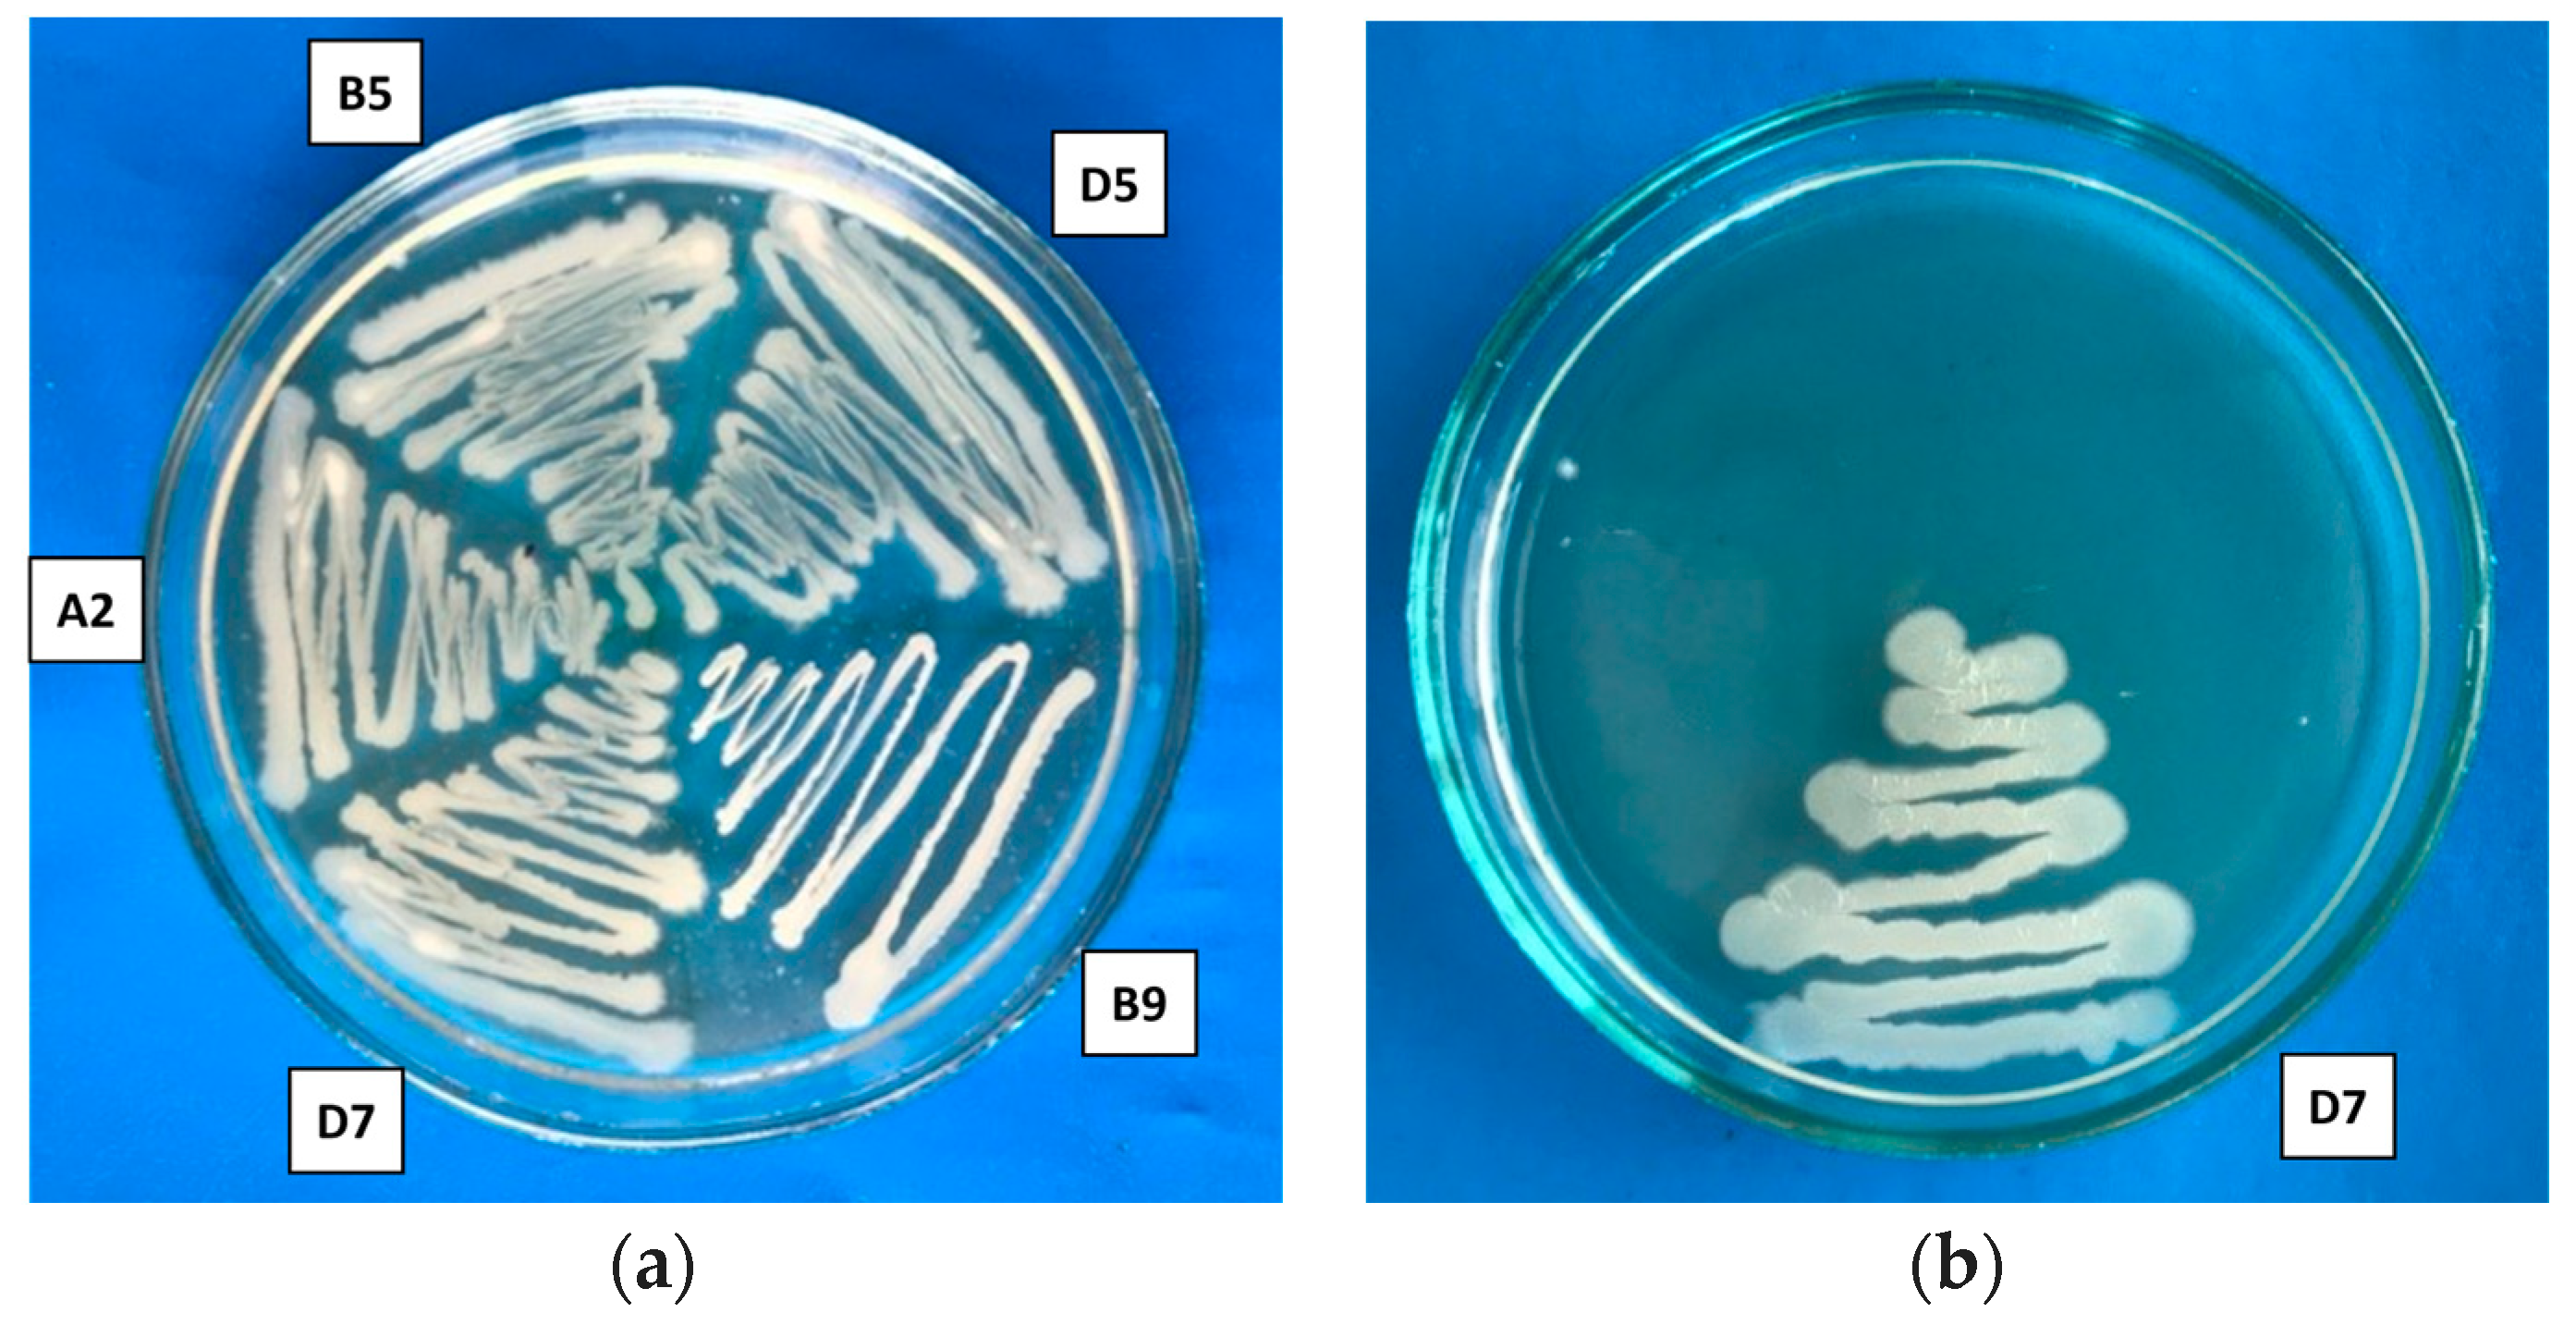
Polymers 16 00376 g002

Biopolymers as Seed-Coating Agent to Enhance Microbially Induced Tolerance of Barley to Phytopathogens
Abstract
1. Introduction
2. Materials and Methods
- Bacillus aerophilus A2 (accession number OQ569360) isolated from leaves of peppermint (Mentha piperita);
- Pseudomonas flavescens D5 (accession number OP642636) isolated from flowers of common chicory (Cichórium intybus);
- Serratia proteamaculans B5 (accession number OR858823) isolated from the leaves of Iris;
- Bacillus simplex B9 (accession number OR864231) isolated from the roots of wormwood (Artemisia absinthium);
- Pseudomonas putida D7 (accession number OR863903) isolated from the roots of Echinacea (Echinacea purpurea);
- Aureobasidium pullulans C7 (accession number OR864236) isolated from dark chestnut soil;
- Bacillus thuringiensis C8 (accession number OR858828) isolated from the surface of apples.
2.1. Production of IAA
2.2. The Antifungal Properties of Microorganisms
2.3. Determination of Microbial Halotolerance
2.4. PHA Production Assay
2.5. Microbe–Microbe In Vitro Compatibility Test
2.6. Extraction of Polysaccharide
2.7. Measurement of Dynamic Viscosity
2.8. Development of Various Options for Processing Barley Seeds
2.9. Pot Experiments
- T1—Untreated seeds;
- T2—Untreated seeds + Fusarium oxysporum;
- T3—Seed treatment with bacterial suspension + Fusarium oxysporum;
- T4—Seed coating with polymeric mixture + Fusarium oxysporum;
- T5—Simultaneous seed coating with bacterial suspension and polymeric mixture of Fusarium oxysporum.
2.10. Determination of Free Proline Concentration
2.11. Determination of Chlorophyll Concentration
2.12. Preparation of the Extract for the Determination of Antioxidant Enzymes
2.12.1. Investigation of Catalase Activity
2.12.2. Investigation of Ascorbate Peroxidase Activity
2.12.3. Investigation of Guaiacol Peroxidase Activity
2.13. Statistical Analysis
3. Results
3.1. Characterization of the Biological Activity of Endophytic Bacteria
3.2. Biocompatibility Assessment of Strains
3.3. Biosynthesis of Microbial Exopolysaccharides and Their Rheological Properties
3.4. The Use of Various Antifungal Formulations for Seed Treatments in Pot Experiments
4. Conclusions
Author Contributions
Funding
Institutional Review Board Statement
Informed Consent Statement
Data Availability Statement
Acknowledgments
Conflicts of Interest
References
- Karlsson, I.; Persson, P.; Friberg, H. Fusarium Head Blight From a Microbiome Perspective. Front. Microbiol. 2021, 12, 628373. [Google Scholar] [CrossRef]
- Korbecka-Glinka, G.; Piekarska, K.; Wi’sniewska-Wrona, M. The Use of Carbohydrate Biopolymers in Plant Protection against Pathogenic Fungi. Polymers 2022, 14, 2854. [Google Scholar] [CrossRef]
- Lopez-Moya, F.; Suarez-Fernandez, M.; Lopez-Llorca, L.V. Molecular mechanisms of chitosan interactions with fungi and plants. Int. J. Mol. Sci. 2019, 20, 332. [Google Scholar] [CrossRef] [PubMed]
- Xing, K.; Zhu, X.; Peng, X.; Qin, S. Chitosan antimicrobial and eliciting properties for pest control in agriculture. Agron. Sustain. Dev. 2015, 35, 569. [Google Scholar] [CrossRef]
- Zheng, F.; Chen, L.; Zhang, P.F.; Zhou, J.Q.; Lu, X.F.; Tian, W. Carbohydrate polymers exhibit great potential as effective elicitors in organic agriculture: A review. Carbohydr. Polym. 2020, 230, 115637. [Google Scholar] [CrossRef] [PubMed]
- Chin, J.M.; Lim, Y.Y.; Ting, A.S.Y. Biopolymers for biopriming of Brassica rapeseeds: A study on coating efficacy, bioagent viability and seed germination. J. Saudi Soc. Agric. Sci. 2021, 20, 198. [Google Scholar] [CrossRef]
- Jurado, M.M.; Suárez-Estrella, F.; Toribio, A.J.; Martínez-Gallardo, M.R.; Estrella-González, M.J.; López-González, J.A.; López, M.J. Biopriming of cucumber seeds using actinobacterial formulas as a novel protection strategy against Botrytis cinerea. Front. Sustain. Food Syst. 2023, 7, 1158722. [Google Scholar] [CrossRef]
- Ren, X.X.; Chen, C.; Ye, Z.H.; Su, X.Y.; Xiao, J.J.; Liao, M.; Cao, H.Q. Development and Application of Seed Coating Agent for the Control of Major Soil-Borne Diseases Infecting Wheat. Agronomy 2019, 9, 413. [Google Scholar] [CrossRef]
- Singh, R.S.; Kaur, N.; Kennedy, J.F. Pullulanproductionfromagro-industrialwasteanditsapplicationsinfoodindustry: A review. Carbohydr. Polym. 2019, 217, 46. [Google Scholar] [CrossRef]
- Mahmoud, Y.A.; El-Naggar, M.E.; Abdel-Megeed, A.; El-Newehy, M. Recent Advancements in Microbial Polysaccharides: Synthesis and Applications. Polymers 2021, 13, 4136. [Google Scholar] [CrossRef]
- Behera, S.; Priyadarshanee, M.; Vandana, D.S. Polyhydroxyalkanoates, the bioplastics of microbial origin. Properties. Biochemical synthesis and their applications. Chemosphere 2022, 294, 133723. [Google Scholar] [CrossRef]
- Nor Azillah, F.O.; Sarala, S.; Noriaki, S. Biodegradable dual-layer Polyhydroxyalkanoate (pha)/Polycaprolactone (pcl) mulch film for agriculture. Energy Nexus 2022, 8, 100137. [Google Scholar]
- Ma, L.; Zhang, Z.; Li, J.; Yang, X.; Fei, B.; Leung, P.H.M.; Tao, X.M. A New Antimicrobial Agent: Poly (3-Hydroxybutyric Acid) Oligomer. Macromol. Biosci. 2019, 19, 1800432. [Google Scholar] [CrossRef]
- Abou-Aiad, T.H.M. Morphology and Dielectric Properties of Polyhydroxybutyrate (PHB)/Poly(Methylmethacrylate)(PMMA) Blends with Some Antimicrobial Applications. Polym. Plast. Technol. Eng. 2007, 46, 435. [Google Scholar] [CrossRef]
- Ignatova, L.; Usmanova, A.; Brazhnikova, Y.; Omirbekova, A.; Egamberdieva, D.; Mukasheva, T.; Kistaubayeva, A.; Savitskaya, I.; Karpenyuk, T.; Goncharova, A. Plant Probiotic Endophytic Pseudomonas flavescens D5 Strain for Protection of Barley Plants from Salt Stress. Sustainability 2022, 14, 15881. [Google Scholar] [CrossRef]
- Ignatova, L.; Brazhnikova, Y.; Omirbekova, A.; Usmanova, A. Polyhydroxyalkanoates (PHAs) from Endophytic Bacterial Strains as Potential Biocontrol Agents against Postharvest Diseases of Apples. Polymers 2023, 15, 2184. [Google Scholar] [CrossRef] [PubMed]
- Abulfaraj, A.; Jalal, R. Use of plant growth-promoting bacteria to enhance salinity stress in soybean (Glycine max L.) plants. Saudi J. Biol. Sci. 2021, 28, 3823. [Google Scholar] [CrossRef]
- Sharma, N. Polyhydroxybutyrate (PHB) Production by Bacteria and Its Application as Biodegradable Plastic in Various Industries. Acad. J. Polym. Sci. 2019, 2, 3. [Google Scholar] [CrossRef]
- Mostafa, Y.S.; Alrumman, S.A.; Otaif, K.A.; Alamri, S.A.; Mostafa, M.S.; Sahlabji, T. Production and Characterization of Bioplastic by Polyhydroxybutyrate Accumulating Erythrobacter aquimaris Isolated from Mangrove Rhizosphere. Molecules 2020, 25, 179. [Google Scholar] [CrossRef]
- Mahitha, G.; Jaya, M.R. Microbial polyhydroxybutyrate production by using cheap raw materials as substrates. Indian J. Pharm. Biol. Res. 2016, 4, 57. [Google Scholar] [CrossRef]
- Siddiqui, I.A.; Shaukat, S.S. Combination of Pseudomonas Aeruginosa and Pochonia Chlamydosporia for Control of Root- Infecting Fungi in Tomato. J. Phytopathol. 2003, 151, 215. [Google Scholar] [CrossRef]
- Goksungur, Y.; Uzunogullari, P.; Dagbagli, S. Optimization of pullulan production from hydrolysed potato starch waste by response surface methodology. Carbohydr. Polym. 2011, 83, 1330. [Google Scholar] [CrossRef]
- Oliveira, V.C. Study of the Molecular Weight of Pullulan Produced by Aureobasidium pullulans from Industrial Waste. Mater. Res. 2023, 26, e20230060. [Google Scholar] [CrossRef]
- Bates, L.E.; Waldre, R.P.; Teare, I.D. Rapid determination of free proline for water stress studies. Plant Soil. 1973, 39, 205. [Google Scholar] [CrossRef]
- Lichtestaller, H.K. Determination of total carotenoids and chlorophylls a and b of leaves extracts in different solvents. Biochem. Soc. Trans. 1983, 11, 591. [Google Scholar]
- Al-Taweel, K.; Iwaki, T.; Yabuta, Y. A bacterial transgene for catalase protects translation of D1 protein during exposure of salt-stressed tobacco leaves to strong light. Plant Physiol. 2007, 145, 258–265. [Google Scholar] [CrossRef] [PubMed]
- Khor, S.; Rahmad, Z.; Sreeramanan, S. Ascorbate Peroxidase Activity of Aranda Broga Blue Orchid Protocorm-like Bodies (PLBs) In Response to PVS2 Cryopreservation Method. Trop. Life Sci. Res. 2016, 1, 139. [Google Scholar] [CrossRef] [PubMed]
- Mika, A.; Lüthje, S. Properties of Guaiacol Peroxidase Activities Isolated from Corn Root Plasma Membranes. Plant Physiol. 2003, 132, 1489. [Google Scholar] [CrossRef] [PubMed]
- Afzal, I.; Shinwari, Z.K.; Sikandar, S.; Shahzad, S. Plant Beneficial Endophytic Bacteria: Mechanisms, Diversity, Host Range and Genetic Determinants. Microbiol. Res. 2019, 221, 36. [Google Scholar] [CrossRef] [PubMed]
- Dhungana, S.A.; Itoh, K. Effects of Co-Inoculation of Indole-3-Acetic Acid-Producing and -Degrading Bacterial Endophytes on Plant Growth. Horticulturae 2019, 5, 17. [Google Scholar] [CrossRef]
- Khianngam, S.; Meetum, P.; Chiangmai, P.N.; Tanasupawat, S. Identification and Optimisation of Indole-3-Acetic Acid Production of Endophytic Bacteria and Their Effects on Plant Growth. Trop. Life Sci. Res. 2023, 34, 219. [Google Scholar] [CrossRef] [PubMed]
- Yu, J.; Pedroso, I.R. Mycotoxins in Cereal-Based Products and Their Impacts on the Health of Humans. Livestock Animals and Pets. Toxins 2023, 15, 480. [Google Scholar] [CrossRef] [PubMed]
- Newitt, J.T.; Prudence, S.M.M.; Hutchings, M.I.; Worsley, S.F. Biocontrol of Cereal Crop Diseases Using Streptomycetes. Pathogens 2019, 8, 78. [Google Scholar] [CrossRef] [PubMed]
- Behera, T.K.; Krishna, R.; Ansari, W.A.; Aamir, M.; Kumar, P.; Kashyap, S.P.; Pandey, S.; Kole, C. Approaches Involved in the Vegetable Crops Salt Stress Tolerance Improvement: Present Status and Way Ahead. Front. Plant Sci. 2022, 12, 787292. [Google Scholar] [CrossRef] [PubMed]
- Corral, P.; Amoozegar, M.A.; Ventosa, A. Halophiles and Their Biomolecules. Recent Advances and Future Applications in Biomedicine. Mar. Drugs 2019, 18, 33. [Google Scholar] [CrossRef] [PubMed]
- Thomloudi, E.E.; Tsalgatidou, P.C.; Douka, D.; Spantidos, T.N.; Dimou, M.; Venieraki, A.; Katinakis, P. Multistrainversus Single-Strain Plant Growth Promoting Microbial Inoculants. The Compatibility Issue. Hell. Plant Prot. J. 2019, 12, 61. [Google Scholar]
- Paravar, A.; Piri, R.; Balouchi, H.; Ma, Y. Microbial seed coating: An attractive tool for sustainable agriculture. Biotechnol. Rep. 2023, 37, e00781. [Google Scholar] [CrossRef]
- Zhubanova, A.A.; Ernazarova, A.K.; Kaiyrmanova, G.K.; Zayadan, B.K.; Savitskaya, I.S.; Abdieva, G.Z.; Kistaubaeva, A.S.; Akimbekov, N.S. Construction of cyanobacterial-bacterial consortium on the basis of axenic cyanobacterial cultures and heterotrophic bacteria cultures for bioremediation of oil-contaminated soils and water ponds. Russ. J. Plant Physiol. 2013, 60, 555. [Google Scholar] [CrossRef]
- Ma, Y. Seed coating with beneficial microorganisms for precision agriculture. Biotechnol. Adv. 2019, 37, 107423. [Google Scholar] [CrossRef]
- Sohail, M.N.; Tahira, P.; Charles, H. Recent Advances in Seed Coating Technologies: Transitioning Toward Sustainable Agriculture. Green Chem. 2022, 5, 225. [Google Scholar] [CrossRef]
- Brazhnikova, Y.V.; Mukasheva, T.D.; Ignatova, L.V. Shtamm Drojjepodobnogo Griba Aureobasidium pullulans C7—Producent Ekzopolisaharida i Indoliluksusnoi Kisloti [Strain of Yeast-like Fungus Aureobasidium pullulans C7—PRODUCER of Exopolysaccharide and Indolylacetic Acid]. RK Patent No. 32992, 6 August 2018. [Google Scholar]
- Duan, X.; Chi, Z.; Li, H. High pullulan yield is related to low UDP-glucose level and high pullulan-related synthases activity in Aureobasidium pullulans Y68. Ann. Microbiol. 2007, 57, 243. [Google Scholar] [CrossRef]
- Chi, Z.; Wang, F.; Chi, Z.; Yue, L.; Liu, G.; Zhang, T. Bioproducts from Aureobasidium pullulans, a biotechnologically important yeast. Appl. Microbiol. Biotechnol. 2009, 82, 793. [Google Scholar] [CrossRef] [PubMed]
- Wang, Z.; Sheng, J.; Tian, X.; Wu, T.; Liu, W.; Shen, L. Optimization of the production of exopolysaccharides by Bacillus thuringiensis 27 in sand biological soil crusts and its bioflocculant activity. Afr. J. Microbiol. Res. 2011, 5, 207. [Google Scholar]
- Malick, A.; Khodaei, N.; Benkerroum, N.; Karboune, S. Production of exopolysaccharides by selected Bacillus strains: Optimization of media composition to maximize the yield and structural characterization. Int. J. Biol. Macromol. 2017, 102, 539. [Google Scholar] [CrossRef]
- Lee, Y.K.; Jung, S.K.; Chang, Y.H. Rheological properties of a neutral polysaccharide extracted from maca (Lepidium meyenii Walp.) roots with prebiotic and anti-inflammatory activities. Int. J. Biol. Macromol. 2020, 152, 757. [Google Scholar] [CrossRef]
- Hosseini, E.; Mozafari, H.; Hojjatoleslamy, M.; Rousta, E. Influence of temperature, pH and salts on rheological properties of bitter almond gum. Food Sci. Technol. 2017, 37, 437–443. [Google Scholar] [CrossRef]
- Haghighatpanah, N.M. Optimization and characterization of pullulan produced by a newly identified strain of Aureobasidium pullulans. Int. J. Biol. Macromol. 2020, 152, 305–313. [Google Scholar] [CrossRef]
- TeránHilares, R.; Resende, J.; Orsi, C.A.; Ahmed, M.A.; Lacerda, T.M.; Santos, J.C. Exopolysaccharide (pullulan) production from sugarcane bagasse hydrolysate aiming to favor the development of biorefineries. Int. J. Biol. Macromol. 2019, 15, 169. [Google Scholar]
- Farris, S.; Unalan, I.U.; Introzzi, L.; Fuentes-Alventosa, J.M.; Cozzolino, C.A. Pullulan-based films and coatings for food packaging: Present applications, emerging opportunities, and future challenges. J. Appl. Polym. Sci. 2014, 131, 40539. [Google Scholar] [CrossRef]
- Li, R. Electrospinning pullulan fibers from salt solutions. Polymers 2017, 9, 32. [Google Scholar] [CrossRef]
- Munhuweyi, K.; Mpai, S.; Sivakumar, D. Extension of avocado fruit postharvest 591 quality using non-chemical treatments. Agronomy 2020, 10, 212. [Google Scholar] [CrossRef]
- Pirzada, T.; Farias, B.V.; Mathew, R.; Guenther, R.H.; Byrd, M.V.; Sit, T.L.; Pal, L.; Opperman, C.H.; Khan, S.A. Recent Advances in Biodegradable Matrices for Active Ingredient Release inCrop Protection: Towards Attaining Sustainability in Agriculture. Curr. Opin. Colloid Interface Sci. 2020, 48, 121. [Google Scholar] [CrossRef] [PubMed]
- Rocha, I.; Ma, Y.; Souza-Alonso, P.; Vosátka, M.; Freitas, H.; Oliveira, R.S. Seed Coating: A Tool for Delivering Beneficial Microbes to Agricultural Crops. Front. Plant Sci. 2019, 10, 1357. [Google Scholar] [CrossRef] [PubMed]
- Gouda, S.; Kerry, R.G.; Das, G.; Paramithiotis, S.; Shin, H.S. Revitalization of plant growth promoting rhizobacteria for sustainable development in agriculture. Microbiol. Res. 2018, 206, 131. [Google Scholar] [CrossRef] [PubMed]
- Moustaka, J.; Moustakas, M. Early-Stage Detection of Biotic and Abiotic Stress on Plants by Chlorophyll Fluorescence Imaging Analysis. Biosensors 2023, 13, 796. [Google Scholar] [CrossRef] [PubMed]
- Stamelou, M.L.; Sperdouli, I.; Pyrri, I.; Adamakis, I.D.S.; Moustakas, M. Hormetic responses of photosystem II in tomato to Botrytis cinerea. Plants 2021, 10, 521. [Google Scholar] [CrossRef] [PubMed]
- Suárez, J.C.; Vanegas, J.I.; Contreras, A.T.; Anzola, J.A.; Urban, M.O.; Beebe, S.E.; Rao, I.M. Chlorophyll fluorescence imaging as a tool for evaluating disease resistance of common bean lines in the western Amazon region of Colombia. Plants 2022, 11, 1371. [Google Scholar] [CrossRef]
- Legendre, R.; Basinger, N.T.; van Iersel, M.W. Low-cost chlorophyll fluorescence imaging for stress detection. Sensors 2021, 21, 2055. [Google Scholar] [CrossRef]
- Asfi, M.; Ouzounidou, G.; Panajiotidis, S.; Therios, I.; Moustakas, M. Toxicity effects of olive-mill wastewater on growth, photosynthesis and pollen morphology of spinach plants. Ecotoxicol. Environ. Saf. 2012, 80, 69. [Google Scholar] [CrossRef]
- Guidi, L.; Calatayud, A. Non-invasive tool to estimate stress-induced changes in photosynthetic performance in plants inhabiting Mediterranean areas. Environ. Exp. Bot. 2014, 103, 42. [Google Scholar] [CrossRef]
- Zandi, P.; Schnug, E. Reactive Oxygen Species, Antioxidant Responses and Implications from a Microbial Modulation Perspective. Biology 2022, 11, 155. [Google Scholar] [CrossRef]
- Sahu, P.K.; Jayalakshmi, K.; Tilgam, J.; Gupta, A.; Nagaraju, Y.; Kumar, A.; Hamid, S.; Singh, H.V.; Minkina, T.; Rajput, V.D.; et al. ROS generated from biotic stress: Effects on plants and alleviation by endophytic microbes. Front. Plant Sci. 2022, 13, 1042936. [Google Scholar] [CrossRef]
- Liang, X.; Zhang, L.; Natarajan, S.K.; Becker, D.F. Proline mechanisms of stress survival. Antioxid. Redox Signal. 2013, 19, 998. [Google Scholar] [CrossRef]
- Ma, Y.; Rajkumar, M.; Oliveira, R.S.; Zhang, C.; Freitas, H. Potential of plant beneficial bacteria and arbuscular mycorrhizal fungi in phytoremediation of metal-contaminated saline soils. J. Hazard. Mater. 2019, 379, 120813. [Google Scholar] [CrossRef]
- Singh, R.P.; Jha, P.N. The PGPR Stenotrophomona smaltophilia SBP-9 augments resistance against biotic and abiotic stress in wheat plants. Front. Microbiol. 2017, 8, 1945. [Google Scholar] [CrossRef]
- Piri, R.; Moradi, A.; Balouchi, H.; Salehi, A. Improvement of cumin (Cuminum cyminum) seed performance under drought stress by seed coating and biopriming. Sci. Hortic. 2019, 257, 21. [Google Scholar] [CrossRef]
- Bhattacharyya, C.; Banerjee, S.; Acharya, U. Evaluation of plant growth promotion properties and induction of antioxidative defense mechanism by tea rhizobacteria of Darjeeling. Sci. Rep. 2020, 10, 15536. [Google Scholar] [CrossRef]
- Neshat, M.; Abbasi, A.; Hosseinzadeh, A.; Sarikhani, M.R.; Dadashi Chavan, D.; Rasoulnia, A. Plant growth promoting bacteria (PGPR) induce antioxidant tolerance against salinity stress through biochemical and physiological mechanisms. Physiol. Mol. Biol. Plants. 2022, 28, 347. [Google Scholar] [CrossRef]

| Strains | Properties | |||||
|---|---|---|---|---|---|---|
| IAA, μg mL−1 | Zone of Inhibition of Phytopathogen Growth, cm | Halotolerance | PHA Production, g L−1 | |||
| Fusarium solani | Fusarium oxysporum | 5% NaCl | 15% NaCl | |||
| Pseudomonas flavescens D5 | 45.2 ± 2.1 a | - | 3.0 ± 0.1 b | + | 2.77 ± 0.07 a | |
| Bacillus aerophillus A2 | 52.4 ± 2.1 b | - | - | + | 4.54 ± 0.08 b | |
| Serratia proteamaculans B5 | 62.7 ± 2.1 c | 2.6 ± 0.1 b | - | + | ||
| Bacillus simplex B9 | - | 2.1 ± 0.05 a | 1.8 ± 0.05 a | + | ||
| Pseudomonas putida D7 | 69.2 ± 3.1 c | - | - | + | + | |
| Strain | Pseudomonas flavescens D5 | Bacillus aerophillus A2 | Serratia proteamaculans B5 | Bacillus simplex B9 | Pseudomonas putida D7 |
|---|---|---|---|---|---|
| Pseudomonas flavescens D5 | |||||
| Bacillus aerophillus A2 | + | ||||
| Serratia proteamaculans B5 | + | + | |||
| Bacillus simplex B9 | − | − | + | ||
| Pseudomonas putida D7 | + | + | + | − |
| Strain | The Dry Weight of Cells, g L−1 (X) | Production of EPS, g L−1 (P) | Utilized Glucose, g L−1 (S) | The yield Coefficient for Biomass P/X, % | The yield Coefficient for Substrate P/S, % |
|---|---|---|---|---|---|
| A. pullulans C7 | 3.59 ± 0.13 | 12.53 ± 0.48 | 17.12 ± 0.81 | 349.02 | 73.19 |
| B. thuringiensis C8 | 1.86 ± 0.06 | 3.97 ± 0.15 | 10.15 ± 0.61 | 213.44 | 39.11 |
| Treatment Variants | Dry Mass of stem, g | Dry Mass of Root, g | Length of Stem, cm | Length of Root, cm |
|---|---|---|---|---|
| T1 | 1.2 ± 0.03 d | 0.9 ± 0.04 a | 22.0 ± 0.9 c | 11.5 ± 0.5 b |
| T2 | 0.6 ± 0.02 a | 0.8 ± 0.03 a | 15.0 ± 0.7 a | 8.5 ± 0.3 a |
| T3 | 1.1 ± 0.04 c | 0.9 ± 0.04 a | 22.5 ± 0.9 c | 12.5 ± 0.2 c |
| T4 | 0.9 ± 0.03 b | 1.3 ± 0.02 c | 20.8 ± 0.8 b | 11.0 ± 0.5 b |
| T5 | 1.0 ± 0.03 c | 1.2 ± 0.03 b | 23.8 ± 0.9 c | 13.6 ± 0.5 d |
| Treatment Variant | Proline Content, mg g−1 | Chlorophyll a Content, mg g−1 | Chlorophyll b Content, mg g−1 | Total Chlorophyll Content (a + b), mg g−1 |
|---|---|---|---|---|
| T1 | 0.94 ± 0.03 a | 1.89 ± 0.07 e | 0.94 ± 0.02 e | 2.83 ± 0.1 e |
| T2 | 1.70 ± 0.07 e | 0.69 ± 0.02 a | 0.34 ± 0.01 a | 1.03 ± 0.04 a |
| T3 | 1.4 ± 0.03 d | 1.23 ± 0.04 c | 0.57 ± 0.02 b | 1.8 ± 0.07 b |
| T4 | 1.22 ± 0.04 c | 0.94 ± 0.03 b | 0.68 ± 0.03 c | 1.62 ± 0.05 c |
| T5 | 1.1 ± 0.03 b | 1.42 ± 0.03 d | 0.81 ± 0.04 d | 2.23 ± 0.07 d |
| Treatment Variant | Catalase, mol min−1 mg of Protein −1 | Ascorbate Peroxidase, mol min−1 mg of Protein−1 | Guaiacol Peroxidase, mol min−1 mg of Protein−1 |
|---|---|---|---|
| T1 | 0.12 ± 0.005 a | 9.6 ± 0.3 a | 4.8 ± 0.2 a |
| T2 | 0.23 ± 0.004 b | 12.47 ± 0.2 c | 7.14 ± 0.3 b |
| T3 | 0.34 ± 0.007 d | 12.34 ± 0.5 c | 6.7 ± 0.3 b |
| T4 | 0.35 ± 0.007 d | 10.03 ± 0.5 b | 6.9 ± 0.3 b |
| T5 | 0.29 ± 0.006 c | 30.37 ± 0.9 d | 19.2 ± 0.7 c |
Disclaimer/Publisher’s Note: The statements, opinions and data contained in all publications are solely those of the individual author(s) and contributor(s) and not of MDPI and/or the editor(s). MDPI and/or the editor(s) disclaim responsibility for any injury to people or property resulting from any ideas, methods, instructions or products referred to in the content. |
© 2024 by the authors. Licensee MDPI, Basel, Switzerland. This article is an open access article distributed under the terms and conditions of the Creative Commons Attribution (CC BY) license (https://creativecommons.org/licenses/by/4.0/).
Share and Cite
Usmanova, A.; Brazhnikova, Y.; Omirbekova, A.; Kistaubayeva, A.; Savitskaya, I.; Ignatova, L. Biopolymers as Seed-Coating Agent to Enhance Microbially Induced Tolerance of Barley to Phytopathogens. Polymers 2024, 16, 376. https://doi.org/10.3390/polym16030376
Usmanova A, Brazhnikova Y, Omirbekova A, Kistaubayeva A, Savitskaya I, Ignatova L. Biopolymers as Seed-Coating Agent to Enhance Microbially Induced Tolerance of Barley to Phytopathogens. Polymers. 2024; 16(3):376. https://doi.org/10.3390/polym16030376
Chicago/Turabian StyleUsmanova, Aizhamal, Yelena Brazhnikova, Anel Omirbekova, Aida Kistaubayeva, Irina Savitskaya, and Lyudmila Ignatova. 2024. "Biopolymers as Seed-Coating Agent to Enhance Microbially Induced Tolerance of Barley to Phytopathogens" Polymers 16, no. 3: 376. https://doi.org/10.3390/polym16030376
APA StyleUsmanova, A., Brazhnikova, Y., Omirbekova, A., Kistaubayeva, A., Savitskaya, I., & Ignatova, L. (2024). Biopolymers as Seed-Coating Agent to Enhance Microbially Induced Tolerance of Barley to Phytopathogens. Polymers, 16(3), 376. https://doi.org/10.3390/polym16030376

